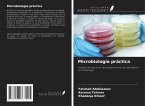
Microbiología práctica

La bacteriología es la rama de la ciencia que se ocupa del estudio de las bacterias. En la actualidad, la investigación bacteriológica ha contribuido directa o indirectamente al desarrollo de la biotecnología. Concepto de Bacteriología Práctica se ha escrito para que los estudiantes comprendan por qué y cómo se realiza cada experimento. Este enfoque pregunta-respuesta incluye técnicas y procedimientos ampliamente utilizados por los investigadores durante los experimentos bacteriológicos. Abarca investigaciones sobre identificación bacteriana, cultivo, crecimiento, metabolismo, genética, tecnología enzimática, nanobiotecnología y otras áreas básicas. Las características más destacadas de este libro son la descripción sencilla de las respuestas a los problemas prácticos, la información de fondo adecuada y la fácil comprensión del procedimiento experimental con razones destacadas. Este libro enseña a aprender la investigación bacteriológica conceptualmente y a desarrollar sólidas habilidades de pensamiento. Los estudiantes e investigadores que trabajan en el campo de la bacteriología encontrarán este libro beneficioso.
Bitte wählen Sie Ihr Anliegen aus.
Rechnungen
Retourenschein anfordern
Bestellstatus
Storno